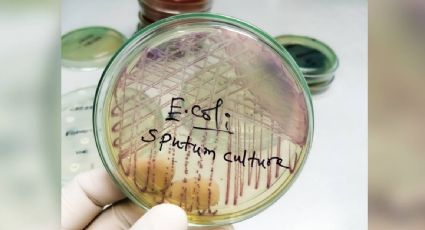
Se elevan a 25 los casos registrados por una intoxicación alimentaria en el norte de Francia

E.COLI
Se elevan a 25 los casos registrados por una intoxicación alimentaria en el norte de Francia
27/6/2025 | Los primeros indicios apuntan a la ingestión de una carne en mal estado y varias carnicerías han cerrado en Saint-Quentin, el municipio más afectado por este brote